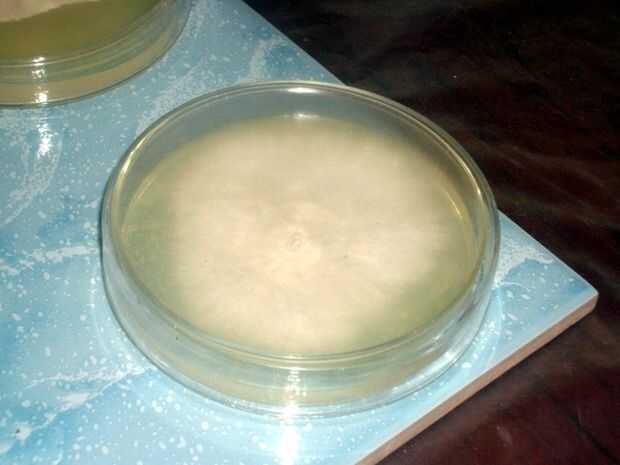

Paso 7: Inoculación II (Agar transferencia de cultivo de tejidos)

Otro método para inocular su grano, es por primera multiplicación del tejido hongo en Agar (o clonación). Mide 5,75 g de polvo de agar nutritivo con 1 taza de agua (suficiente para 5 o más placas de Petri). Comenzar a calentar y revolver hasta que se disuelva completamente el agar. Que comience a hervir, continuar agitar durante un minuto y retire del fuego. Vierta una capa delgada en su platos de Petri y cubrir con las tapas. Envolver en papel de aluminio y cocinar con su grano (o por lo menos 30 minutos a 15 psi) de presión. Mueva los platos de Petri, seta tejido y otros equipos a la sala limpia. Deje que los platos de Petri se enfríe por completo. Rocíe las paredes de la habitación, bancas y pisos con solución de lejía 5% (como limpiar antes de usar ropa, lavarse las manos etc.). Un filtro de banco y hepa de flujo laminar reducir la contaminación durante esta etapa, pero es posible (con una mayor tasa de contaminación) tener éxito sin una.
Tomando la seta por su base, con cuidado lo escupo en dos. Colocar la seta (exterior abajo) sobre una superficie limpia, y asegúrese de mantener el interior tejido de tocar nada. Esterilizar la hoja de bisturí manteniendo dentro de la llama del quemador de alcohol. Levante la tapa de la caja Petri y enfriar la hoja de bisturí colocando centralmente en el agar. Con el bisturí, corte con cuidado una pequeña plaza del tejido seta recién expuesta. Coloque el cuadrado de tejido centralmente en el agar y la cubierta con la tapa de la caja de Petri. Desea la tapa con cinta adhesiva (con una cinta limpia respirable) para reducir la posibilidad de contaminación. Repita el proceso, asegúrese de esterilizar el bisturí antes de cada transferencia. Dejar incubar las cajas Petri.
Incubar pleurotus ostreatus en 24° C (75° F) y pleurotus pulmonarius (verano) 24° C a 30° C (75° F a 85° F). La colonización debe tomar aproximadamente 8 a 10 días.
Durante este tiempo, retire cualquier platos de Petri que parece estar contaminados con otros moldes. Una vez completamente colonizado (micelio cerca de los bordes), es tiempo para transferir el agar al grano esterilizado. Elija sólo los cultivos más saludables para las inoculaciones. Esterilizar la hoja de bisturí, retire la tapa de la caja de Petri y cortar 2 cuñas desde el centro del plato. Quite el aluminio y la tapa de la jarra de grano. Con el bisturí, transferir las cuñas al grano estéril. Rápidamente, empujar una pequeña cantidad de algodón a través del orificio de respiración de la tapa y coloque en la jarra. Por último, agitar el frasco enérgicamente para dispersar el micelio desde el agar en el grano. Colocar en un estante bajo sombra dentro de la sala limpia para incubar (temperaturas que el anterior). Repita para cada frasco de grano esterilizado.
Nota: clonación repetidamente (sin la introducción de nuevas cepas) puede pueda replicar el descoloramiento, con posteriores culturas finalmente perder vitalidad y por lo tanto produce menos hongos. En contraste con la clonación, las esporas cuando germinaron (véase paso 8b), crear muchas cepas diferentes que compiten entre sí. Las características resultantes de hongos por lo tanto pueden variar de cultura a cultura.